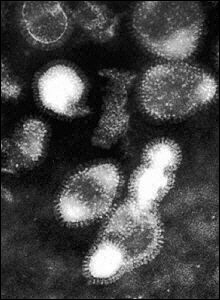

|
Romania culls poultry as EU braces for bird flu
(Reuters)
Updated: 2005-10-16 20:04
AREA CORDONED OFF
Six counties in southeastern Romania have been cordoned off and vehicles
leaving the area are being disinfected at checkpoints. Poultry and pigs have
been put indoors, transport of live animals from the counties forbidden and
fairs selling animals closed across the country, officials said.
"We acted in accordance with European Union decisions," said Gabriel Predoi
of the country's veterinary authority.
The European Commission asked governments on Friday to pinpoint areas most at
risk and to keep poultry separate from wild birds, which carry the virus. EU
veterinary experts will meet on Thursday to review the situation.
Microscopic view of the H5N1 virus.
A British laboratory that tested a sample of a bird flu virus found in
Romania confirmed that it is the the H5N1 strain that has killed more than
60 people in Asia. [AFP/File] | Romanian media
said up to two million vaccine doses for regular flu had been sold in the past
few days, even though it protects people only against the latest strain of human
flu.
"We exhausted all the flu vaccines in stock," said Margareta Dumitrescu, a
pharmacist in downtown Bucharest.
Bulgaria, sandwiched between Romania and Turkey, said it would set up a bird
flu crisis headquarters on Monday.
Bulgaria has stepped up border controls and increased surveillance over
poultry farms along the Danube and Black Sea, chief veterinarian Zheko Baichev
told Reuters.
"We have made 500 blood tests on farm birds and checked on 154 domestic and
100 wild birds found dead throughout the country. We have not isolated the bird
flu virus," he said.
Two EU bird flu experts will arrive in Bulgaria on Monday to help with
preventive measures, Baichev said.
The H5N1 strain first emerged in Hong Kong in 1997, causing the death or
destruction of 1.5 million birds and sickening 18 people, killing six.
It re-emerged in 2003 in South Korea, and has now spread to China, Vietnam,
Thailand, Laos, Indonesia, Turkey and Romania.
|